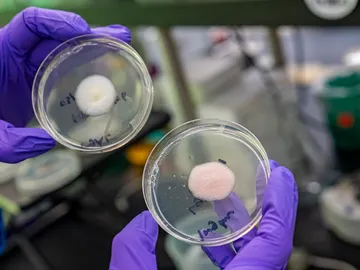

Astronomía, divulgación, descubrimientos, ecología, innovación...

Nuestras neuronas pueden predecir el futuro mientras soñamos

Vaticinan el fin de los smartphones antes de 2030, y su alternativa no te va a convencer

¿Desaparecerá el dinero en efectivo? El futuro de las monedas

Hablar con la mirada es más fácil que nunca gracias a una aplicación

¿Serán infértiles los humanos del futuro?

¿Es peligroso el 5G para la salud?

Supermercados, bares, gimnasios... Así serán en el futuro los sitios que visitas a diario

7 formas en las que los asistentes virtuales te cambiarán la vida

Así es Hyperloop, el transporte del futuro que ya está en periodo de pruebas